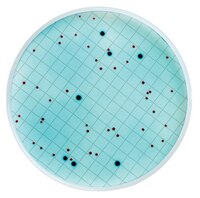

M00PMCB24 Milliporem-ColiBlue24® Broth
For testing drinking water and ambient water. Total coliform and E. coli detection. Beer, Bottled Water, Cider, Soft Drink, Sport Drink, Wine
More>> For testing drinking water and ambient water. Total coliform and E. coli detection. Beer, Bottled Water, Cider, Soft Drink, Sport Drink, Wine Less<<Recommended Products
Overview
| Replacement Information |
|---|
| References |
|---|
| Product Information | |
|---|---|
| HS Code | 3821 00 00 |
| Applicable Device |
|
| Type of Test |
|
| Quality Level | MQ100 |
| Physicochemical Information | |
|---|---|
| pH at 25 °C | pH7.0 ± 0.2 |
| Dimensions | |
|---|---|
| Volume | 2 mL |
| Materials Information |
|---|
| Toxicological Information |
|---|
| Safety Information according to GHS |
|---|
| Safety Information |
|---|
| Product Usage Statements | |
|---|---|
| Certificate Included, Y/N | Y |
| Regulatory Conformance | EPA ; Standard Methods for the Examination of Water and Wastewater |
| Storage and Shipping Information | |
|---|---|
| Storage Temperature | 2 to 8 °C |
| Shelf Life | 12 months |
| Packaging Information | |
|---|---|
| Number Tests/Pk | 50 |
| Material Size | 50 |
| Material Package | 2 mL plastic ampoules |
| Transport Information |
|---|
| Supplemental Information |
|---|
| Specifications |
|---|
| Global Trade Item Number | |
|---|---|
| Catalogue Number | GTIN |
| M00PMCB24 | 04053252496271 |
Documentation
m-ColiBlue24® Broth SDS
| Title |
|---|
Certificates of Quality
Data Sheet
| Title |
|---|
| Data Sheet - m-ColiBlue24 Broth (M00PMCB24) |
| MicropreSure On-Line Filtration Samplers |
| MicropreSure On-Line Filtration Samplers: Ready-to-use devices sample and test in-process bottled water |